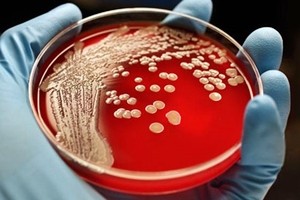

Shu Lam, 25enne studentessa malese all’Università di Melbourne, ha sviluppato una catena di molecole polimeriche in grado di eliminare i “superbug”, ovvero i batteri resistenti agli antibiotici, senza colpire le cellule sane: è quanto pubblica il quotidiano malese Malay Mail. “Ciò che ho scoperto è una nuova classe di agenti antibatterici, che speriamo possano rimpiazzare gli antibiotici: si tratta di molecole a forma di stella, sintetizzabili in laboratorio e costituite da brevi catene proteiche”, ha spiegato Lam. Secondo gli ultimi dati globali sulla resistenza agli antibiotici i “superbug” potrebbero uccidere fino a 10 milioni di persone l’anno e costare cumulativamente 100mila miliardi di dollari di qui al 2050: di qui che le infezioni resistenti agli antibiotici siano state definite “uno dei principali rischi che l’umanità si torva a dover affrontare”. Le nuove molecole – che lacerano le pareti della cellula batterica – sono state testate sui topi, e prima di poterle sperimentare sull’uomo (non prima di cinque anni) saranno necessari altri studi per verificare l’esistenza di eventuali effetti collaterali, anche se i risultati preliminari sembrano mostrare che le cellule sane non vengono influenzate.
Shu Lam, 25enne studentessa malese all’Università di Melbourne, ha sviluppato una catena di molecole polimeriche in grado di eliminare i “superbug”, ovvero i batteri resistenti agli antibiotici, senza colpire le cellule sane: è quanto pubblica il quotidiano malese Malay Mail. “Ciò che ho scoperto è una nuova classe di agenti antibatterici, che speriamo possano rimpiazzare gli antibiotici: si tratta di molecole a forma di stella, sintetizzabili in laboratorio e costituite da brevi catene proteiche”, ha spiegato Lam. Secondo gli ultimi dati globali sulla resistenza agli antibiotici i “superbug” potrebbero uccidere fino a 10 milioni di persone l’anno e costare cumulativamente 100mila miliardi di dollari di qui al 2050: di qui che le infezioni resistenti agli antibiotici siano state definite “uno dei principali rischi che l’umanità si torva a dover affrontare”. Le nuove molecole – che lacerano le pareti della cellula batterica – sono state testate sui topi, e prima di poterle sperimentare sull’uomo (non prima di cinque anni) saranno necessari altri studi per verificare l’esistenza di eventuali effetti collaterali, anche se i risultati preliminari sembrano mostrare che le cellule sane non vengono influenzate.






